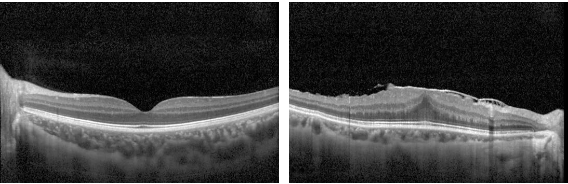
微信截圖_20240805161839

浙江省內及跨省醫保聯網定點醫院
永康市基本醫療保險定點醫院
浙江省“光明快車”定點醫院
永康市兒童青少年近視防控工作指導中心
4001148566
浙江省內及跨省醫保聯網定點醫院
永康市基本醫療保險定點醫院
浙江省“光明快車”定點醫院
永康市兒童青少年近視防控工作指導中心
4001148566
許多老年人在出現視物模糊時
會以為自己是“老花”
事實上
許多眼病都會引起視力下降
比如在老年人中比較常見的黃斑前膜
就與“老花眼”的癥狀十分相似
01什么是黃斑前膜?
黃斑是視網膜上最重要的區域,黃斑前膜是形成于視網膜黃斑表面的一層纖維膜,它與眼睛老化有一定關系,所以常見于老年群體。除了年齡因素之外,患有高度近視、視網膜血管性疾病、糖尿病視網膜病變,或者有過視網膜撕裂、視網膜脫落病史的人,都可能出現黃斑前膜。此外,眼睛受過外傷或手術創傷也可能導致黃斑前膜的產生。
左側為正常黃斑的光學相干斷層掃描圖像,右側為黃斑前膜的光學相干斷層掃描圖像。
02臨床表現有哪些?
由于黃斑前膜剛長出來時呈小片透明狀,且發展非常緩慢。所以,絕大多數患者在早期沒有任何感覺,通常是在做黃斑檢查時意外發現。
黃斑前膜發展到中晚期會出現視力下降、視物變形等。黃斑前膜會收縮拽拉黃斑,導致黃斑向中心部隆起,形成褶皺。當力量大到累及整層視網膜時,就會引起視網膜水腫、變形、撕裂,此時視物就會變形,進而嚴重影響視功能,甚至會發生牽拉性視網膜脫離,后果十分嚴重。
03早發現早治療是關鍵
想要避免黃斑前膜出現晚期嚴重的癥狀,早期發現黃斑前膜非常關鍵!當出現看東西模糊、中心視力明顯下降、看東西顏色變暗、重影、變形等癥狀,需要及時到專業眼科醫院就診。
其次,50歲以上的中老年人群患有黃斑前膜的概率大大增加,均應每半年進行一次眼底檢查,做到早發現、早診斷、早治療。
04專家介紹

王曉鵬
擅長:白內障,眼底病,微創治療淚道疾病
主任醫師,醫學碩士,浙江省醫學會眼科學分會青年委員、金華市醫學會眼科學分會委員。
曾在金華市中心醫院從事眼科臨床工作23年,具有豐富的眼科臨床經驗,熟練掌握眼科常見病及多發病的治療、特別是糖尿病性視網膜病變及老年黃斑變性等眼科疑難雜癥的診斷與治療,熟練開展玻璃體視網膜手術、白內障超聲乳化手術、微創無痛治療淚道疾病等,并率先在金華地區開展鼻內窺鏡治療淚道疾病、甲狀腺相關眼病、眼眶骨折整復術。曾在國家I級刊物及國外SCI刊物發表多篇論文,目前主要致力于淚道、眼眶疾病的微創治療以及玻璃體視網膜等疑難眼病的診治。
門診時間:星期二上午、星期五上午、星期六上午(以實際門診時間為準)